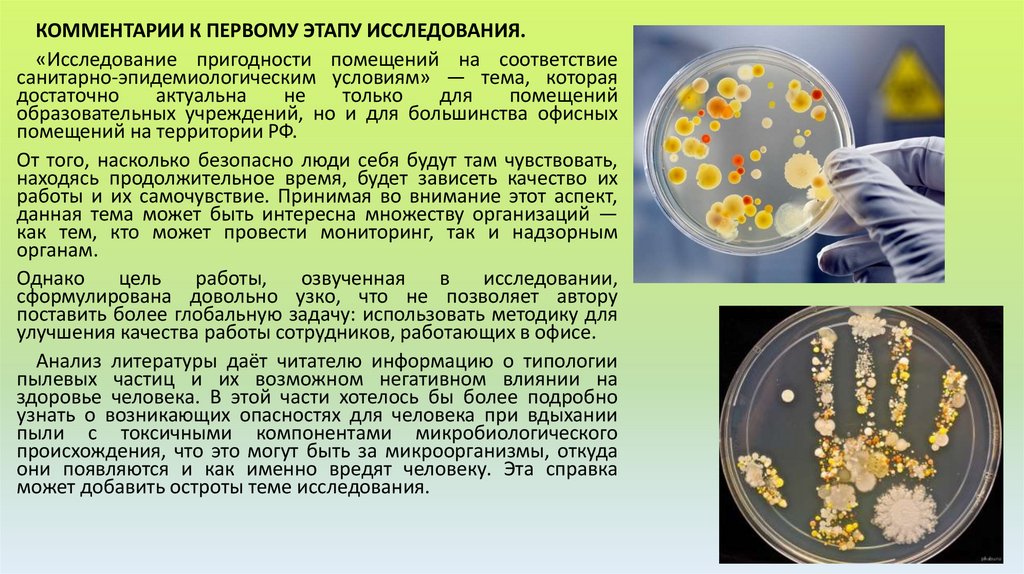
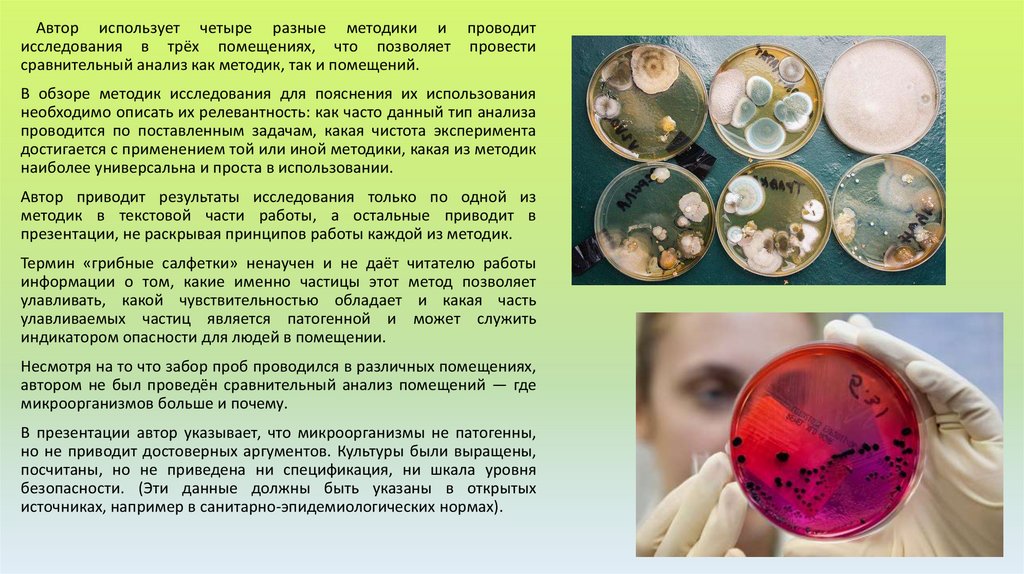
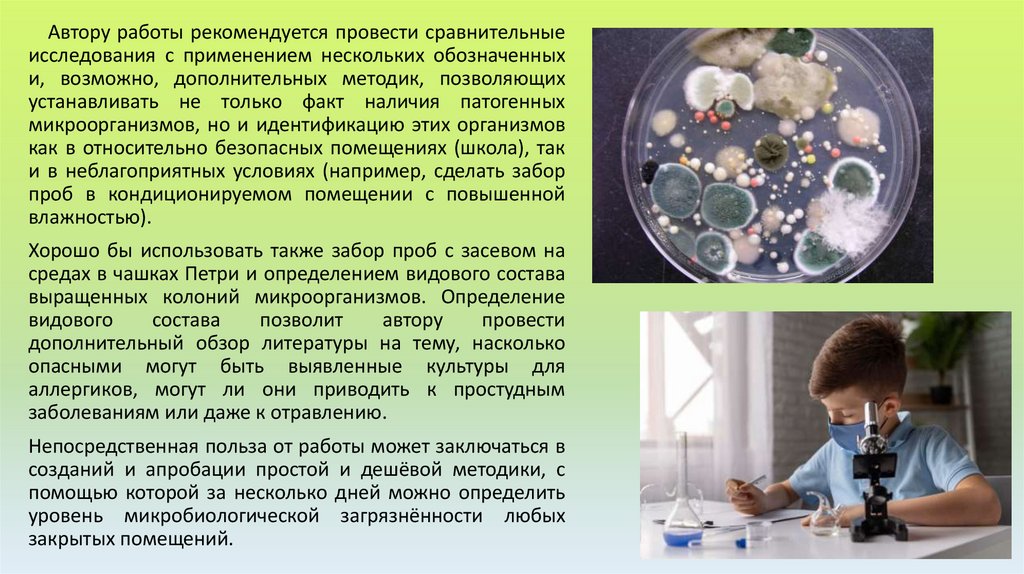

Похожие презентации:
Оценка начального этапа исследования
1.
Оценка начального этапаисследования
2.
Рассмотрим вариант промежуточной экспертной оценки исследования на тему«Исследование смывов естественно загрязнённых поверхностей в общественных местах
микробиологическими методами». Автор — ученица 10 класса, руководитель — учитель
биологии и химии.
Цель. Изучить микробиологическое состояние воздуха помещений школы.
Задачи:
1. Изучить литературу по теме.
2. Провести посев пыли с помощью грибных салфеток.
3. Провести посев пыли на среде RICН.
4. Провести посев пыли на среде Эндо.
5. Зафиксировать результаты проведённых исследований.
6. Проанализировать результаты проведённых исследований.
7. Основываясь на результатах, определить пылевое состояние воздуха помещений
школы.
8. Выработать предложение по разработке комплекса гигиенических мероприятий,
обратить внимание на состояние воздуха в помещениях нашей гимназии.
Актуальность проекта. Все мы знаем, что только здоровый человек с хорошим
самочувствием способен активно жить, успешно преодолевать трудности. Здоровье
человека напрямую зависит от экологического состояния помещений, ведь именно в них
мы проводим около двух третей своей жизни, а значит, и на результаты учеников влияет
состояние окружающего их в учебное время воздуха, таким образом, наш проект не
только поможет поднять уровень моих практических знаний, но и позволит ещё раз
проверить уровень пылевого загрязнения воздуха в помещениях гимназии.
3.
Общие факты о пыли. Пыль представляет собой мелкие имельчайшие твёрдые частицы, размер которых составляет от одной
сотой до 10 мкм. Мельчайшие частицы пыли присутствуют в воздухе
постоянно, более крупные осаждаются постепенно, а самые крупные
— практически сразу.
При инструментальном анализе бытовой пыли было установлено,
что она на 85% состоит из минеральных частиц, на 12% — из бумаги и
волокон тканей, на 19% — из кожных чешуек, на 71% — из цветочной
пыльцы, на 8% — из частиц сажи и дыма.
Пыль различается по химическому составу, по действию на
организм, по форме и по размеру частиц.
• По химическому составу пыль делится
неорганическую, микробиологическую.
на
органическую,
• По действию на организм пыль делится на
дерматотропную, аллергенную и индифферентную.
токсичную,
• По форме пыль делится на аморфную, кристаллическую,
волокнистую, пластинчатую и остроконечную.
• По размеру частиц пыль делится на аэросуспензии и аэрозоли.
Воздух закрытых помещений более насыщен пылью, чем
атмосферный. Человек за сутки вдыхает около 12 тыс. л воздуха, а в
одном только литре содержится примерно 500 тыс. пылинок.
По данным ВОЗ 4—8% преждевременных смертных случаев
объясняются присутствием в окружающем воздухе и воздухе
помещений пылевых частиц. До 20—30% респираторных
заболеваний вызвано загрязнённым воздухом.
4.
Планируемые исследования. Для достижения поставленной цели мы собираемся провести следующиеисследования:
Посев с помощью грибных салфеток.
Посев се помощью среды RICН.
Посев с помощью среды Эндо.
Исследования будут проводиться в трёх помещениях: гардероб (1-й этаж), столовая и спортивный зал.
Проведённые исследования. Из трёх способов изучения микробиологического состояния воздуха в помещениях
гимназии мы на данный момент воспользовались двумя: провели посев с помощью грибных салфеток и среды
RICН. На данный момент окончательные результаты известны только по посеву с помощью грибных салфеток.
Исследование с помощью среды RICН было проведено недавно, поэтому делать выводы пока рано.
Исследование с помощью грибной салфетки проводилось следующим образом:
1. Герметично закрытые грибные салфетки вскрыли перед применением.
2. Протёрли исследуемую поверхность только что вскрытой салфеткой и снова герметично закрыли её.
3. Пропитали салфетки физраствором.
4. Снова герметично закрыли их.
5. Оставили на три дня в месте с примерно постоянной температурой воздуха.
Для исследования понадобились:
1. Грибные салфетки (3 шт.).
2. Физраствор.
3. Фотоаппарат (чтобы зафиксировать результаты).
5.
Первые результаты представлены в таблице.Салфетка № 1
Салфетка № 2
Салфетка № 3
19.10.16
Произведён посев
Произведён посев
Произведён посев
20.10.16
Проявляются колонии грибов
Проявляются колонии грибов
Нет изменений
21.10.16
У
проявившихся
колоний Проявляются новые колонии Проявляются колонии грибов
появляются четкие очертания
грибов и четкие очертания у
ранее проявившихся
Исследования, которые предстоит провести. Для начала нам нужно закончить наши исследования со
средой RICН. Мы ждём проявления результатов посева, затем изучим полученные результаты и сделаем
на их основе выводы. Мы также планируем провести исследования с помощью среды Эндо. К, этим
исследованиям планируем приступить на следующей неделе.
Вывод. Впереди ещё много интересной и важной работы. Наш проект включает использование
нескольких методов, с помощью которых можно более точно установить состояние воздуха в
помещениях гимназии, выяснить, опасен ли он для аллергиков и людей с другими заболеваниями. По
окончании наших исследований мы будем знать не только о количестве пыли в воздухе, но и о её составе,
о наличии или отсутствии в ней спор грибов и бактерий.
6.
КОММЕНТАРИИ К ПЕРВОМУ ЭТАПУ ИССЛЕДОВАНИЯ.«Исследование пригодности помещений на соответствие
санитарно-эпидемиологическим условиям» — тема, которая
достаточно
актуальна
не
только
для
помещений
образовательных учреждений, но и для большинства офисных
помещений на территории РФ.
От того, насколько безопасно люди себя будут там чувствовать,
находясь продолжительное время, будет зависеть качество их
работы и их самочувствие. Принимая во внимание этот аспект,
данная тема может быть интересна множеству организаций —
как тем, кто может провести мониторинг, так и надзорным
органам.
Однако
цель
работы,
озвученная
в
исследовании,
сформулирована довольно узко, что не позволяет автору
поставить более глобальную задачу: использовать методику для
улучшения качества работы сотрудников, работающих в офисе.
Анализ литературы даёт читателю информацию о типологии
пылевых частиц и их возможном негативном влиянии на
здоровье человека. В этой части хотелось бы более подробно
узнать о возникающих опасностях для человека при вдыхании
пыли с токсичными компонентами микробиологического
происхождения, что это могут быть за микроорганизмы, откуда
они появляются и как именно вредят человеку. Эта справка
может добавить остроты теме исследования.
7.
Автор использует четыре разные методики и проводитисследования в трёх помещениях, что позволяет провести
сравнительный анализ как методик, так и помещений.
В обзоре методик исследования для пояснения их использования
необходимо описать их релевантность: как часто данный тип анализа
проводится по поставленным задачам, какая чистота эксперимента
достигается с применением той или иной методики, какая из методик
наиболее универсальна и проста в использовании.
Автор приводит результаты исследования только по одной из
методик в текстовой части работы, а остальные приводит в
презентации, не раскрывая принципов работы каждой из методик.
Термин «грибные салфетки» ненаучен и не даёт читателю работы
информации о том, какие именно частицы этот метод позволяет
улавливать, какой чувствительностью обладает и какая часть
улавливаемых частиц является патогенной и может служить
индикатором опасности для людей в помещении.
Несмотря на то что забор проб проводился в различных помещениях,
автором не был проведён сравнительный анализ помещений — где
микроорганизмов больше и почему.
В презентации автор указывает, что микроорганизмы не патогенны,
но не приводит достоверных аргументов. Культуры были выращены,
посчитаны, но не приведена ни спецификация, ни шкала уровня
безопасности. (Эти данные должны быть указаны в открытых
источниках, например в санитарно-эпидемиологических нормах).
8.
Автору работы рекомендуется провести сравнительныеисследования с применением нескольких обозначенных
и, возможно, дополнительных методик, позволяющих
устанавливать не только факт наличия патогенных
микроорганизмов, но и идентификацию этих организмов
как в относительно безопасных помещениях (школа), так
и в неблагоприятных условиях (например, сделать забор
проб в кондиционируемом помещении с повышенной
влажностью).
Хорошо бы использовать также забор проб с засевом на
средах в чашках Петри и определением видового состава
выращенных колоний микроорганизмов. Определение
видового
состава
позволит
автору
провести
дополнительный обзор литературы на тему, насколько
опасными могут быть выявленные культуры для
аллергиков, могут ли они приводить к простудным
заболеваниям или даже к отравлению.
Непосредственная польза от работы может заключаться в
созданий и апробации простой и дешёвой методики, с
помощью которой за несколько дней можно определить
уровень микробиологической загрязнённости любых
закрытых помещений.
9.
Задания:1. Проанализируйте представленный текст с точки зрения основных
элементов исследовательской деятельности: актуальности, гипотезы,
цели, задач, предмета и объекта исследования, гипотезы, метода и
методики исследования.
2. Какие из приведённых комментариев эксперта представляются вам
наиболее значимыми и полезными? Какие вопросы эксперту вы бы
задали, будь у вас такая возможность?
10.
Используемая литература:М.В.Половкова, А.В.Носов, Т.В.Половкова, М.В.Майсак «Индивидуальный
проект». 10-11 классы: учебное пособие для общеобразовательных
организаций. -3-е изд.- М.: Просвещение, 2021. – 159 с.

Биология
Биология








